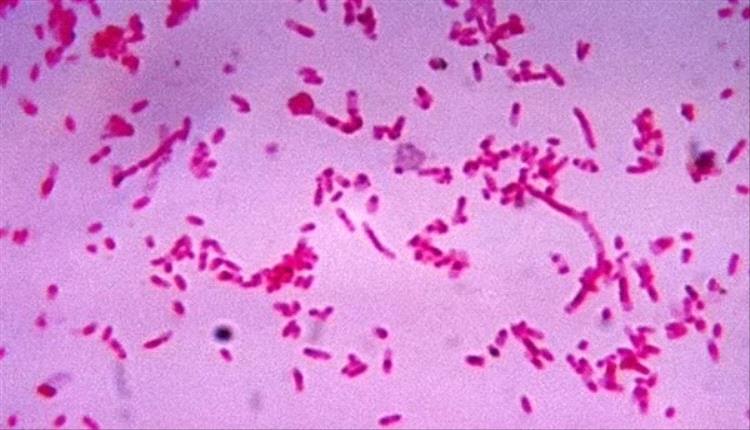

قال علماء بكلية كينجز في لندن، إن البكتيريا الموجودة في الفم قادرة على إذابة بعض أنواع السرطان وتدميرها حيث أن المرضى الذين يعانون من سرطان الرأس والرقبة والذين لديهم بكتيريا الفيوز باكتيريوم داخل الأورام لديهم نتائج أفضل بكثير، وفقًا لـ ديلي ميل البريطانية.
أشار العلماء إلى أنه يجري حاليا بحث بشكل أعمق في الآليات البيولوجية الدقيقة وراء هذا الارتباط من قبل المتخصصين، فقد وضعوا كميات من البكتيريا في أطباق مع خلايا سرطانية وتركوها لعدة أيام، ليجدوا أن عدد خلايا سرطان الرأس والرقبة القابلة للحياة انخفض بنسبة تتراوح بين 70 إلى 99% بعد الإصابة ببكتيريا فيوز باكتيريوم.
وأظهر تحليل آخر أجري على 155 مريضا بسرطان الرأس والرقبة أن أولئك الذين لديهم البكتيريا داخل أورامهم كانت لديهم فرص بقاء أفضل مقارنة بأولئك الذين لا يحملون البكتيريا، مع انخفاض خطر الوفاة بنسبة 65%، لذا يأمل الباحثون أن تساعد هذه النتائج في توجيه العلاج للمرضى المصابين بسرطان الرأس والرقبة والذي يشمل سرطان الفم والحلق وصندوق الصوت والأنف والجيوب الأنفية
وأوضح الخبراء أن التقدم العلاجي في هذا المجال لم يكن كبيرا خلال العشرين عاما الماضية، ومن المؤمل أن يؤدي هذا الاكتشاف إلى علاجات جديدة في المستقبل، بالإضافة إلى أن هذه البكتيريا قادرة على قتل السرطان في مزارع الخلايا، ويكشف هذا البحث أن هذه البكتيريا تلعب دورًا أكثر تعقيدًا مما كان معروفًا سابقًا في علاقتها بالسرطان فهي تذيب خلايا سرطان الرأس والرقبة بشكل أساسي.
تمكن تلك البكتيريا الخبراء في التنبؤ بشكل أفضل بالمرضى الأكثر عرضة للحصول على نتائج جيدة أو أسوأ وبناءً على ذلك، يمكن تغيير علاجهم لجعله أكثر لطفًا مع المرضى الذين لديهم نتائج أفضل، أو جعله أكثر كثافة مع المرضى الذين هم أكثر عرضة لعودة السرطان
![]() تابعوا آخر أخبارنا المحلية وآخر المستجدات السياسية والإقتصادية عبر Google news
تابعوا آخر أخبارنا المحلية وآخر المستجدات السياسية والإقتصادية عبر Google news